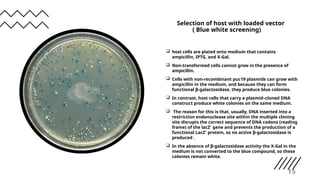
Selection of host with loaded vector
( Blue white screening)
 host cells are plated onto medium that contains
ampicillin, IPTG, and X-Gal.
 Non-transformed cells cannot grow in the presence of
ampicillin.
 Cells with non-recombinant puc19 plasmids can grow with
ampicillin in the medium, and because they can form
functional β-galactosidase, they produce blue colonies.
 In contrast, host cells that carry a plasmid–cloned DNA
construct produce white colonies on the same medium.
 The reason for this is that, usually, DNA inserted into a
restriction endonuclease site within the multiple cloning
site disrupts the correct sequence of DNA codons (reading
frame) of the lacZ′ gene and prevents the production of a
functional LacZ′ protein, so no active β-galactosidase is
produced .
 In the absence of β-galactosidase activity the X-Gal in the
medium is not converted to the blue compound, so these
colonies remain white.
15

The document discusses the puc19 plasmid vector, detailing its types, construction, and utility in molecular biology. It highlights the advantages of puc19, such as its high copy number and the capability for blue-white screening, while noting its limitations in accommodating larger genes. The text outlines key processes like restriction, ligation, transformation, and selection used in recombinant DNA technology.